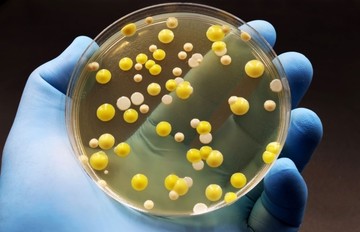
Legyőzhetők a szuperbaktériumok? Magyar kutatók új felfedezése!

Azért ne kapjon rögtön a fertőtlenítőszerekhez! Elmondjuk miért.
Amikor belépünk a fürdőszobánkba, elképzelhető, hogy több száz különböző vírussal kell osztoznunk. Ezek például a fogkefénken vagy a zuhanyrózsán találhatók. Egy új tanulmány szerint számos vírus rejtőzködik a fürdőszobai eszközökön.
A kutatás során a tudósok arra kérték az embereket, hogy küldjék be használt fogkeféiket és mintákat, amelyeket a zuhanyzófejről vettek. A laboratóriumban DNS-szekvenálást alkalmaztak, és több mint 600 különböző vírust azonosítottak – az eredményeket a Frontiers in Microbiomes szaklapban közölték.
"Bár ez első hallásra riasztónak tűnhet, nincs szükség pánikra" – nyugtat meg Erica Hartmann, a tanulmány vezető szerzője, a Northwestern Egyetem környezetmérnöki tanszékének docense.
„A mikrobák mindenhol jelen vannak, de a legtöbbjük ártalmatlan” – magyarázza Hartmann. „Ha túl gyakran használunk fertőtlenítőszereket, a mikrobák ellenállóvá válhatnak, vagy nehezebben kezelhetők lesznek. Jobban járunk, ha elfogadjuk a jelenlétüket.”
Vírusok, amelyek baktériumokat támadnak
A laboratóriumi vizsgálatok során olyan vírusokat találtak, amelyeket bakteriofágoknak neveznek. Ezek a vírusok nem az embereket fertőzik meg, hanem a baktériumokat támadják – azokat is, amelyek súlyos betegségeket okozhatnak nekünk.
Érdekes módon a fogkefékről és a zuhanyfejekről vett minták mindegyike egyedi volt, és a kutatók nem találtak közös mintázatot, amely egyes vírusok elterjedésére utalna bizonyos fürdőszobai környezetekben.
A kutatók azonban gyakrabban találkoztak egy specifikus vírustípussal, a bakteriofággal, amely olyan baktériumokat fertőz meg, amelyek például lepra, tuberkulózis és krónikus tüdőbetegségek kialakulásáért felelősek.
A vírusok, mint a jövő gyógyszerei
A kutatók szerint lehetséges, hogy a jövőben a bakteriofágokat felhasználják majd a baktériumok által okozott betegségek kezelésére. Ezek a vírusok segíthetnek olyan fertőzések gyógyításában, amelyekre az antibiotikumok már nem hatnak.
„A penicillint is véletlenül fedezték fel egy penészes kenyéren” – említi Hartmann. „Lehetséges, hogy a következő nagy áttörés egy olyan vírusból származik, ami a fogkeféjén telepedett meg.”
Bár ez a kutatás egyelőre csak előzetes laboratóriumi eredményeket mutat, a bakteriofágokkal kapcsolatos további kutatások reményt nyújthatnak arra, hogy egy nap orvosi kezelések részévé válhatnak. Az út a laboratóriumi tesztektől a klinikai vizsgálatokig hosszú, és sok évnyi kutatómunkát igényel.
„Természetesen fontos, hogy a fürdőszobát és az eszközeit tisztán tartsa, mivel ez hatékony módja a káros baktériumok számának csökkentésére, ugyanúgy, ahogy a gyakori kézmosás is segít. A bakteriofágok miatt viszont nem kell aggódnia – ők a barátaink” – mondja Hatfull.
Ez a tanulmány érdekes bepillantást nyújt abba, milyen mikrobák vesznek körül minket a mindennapjainkban, még a saját otthonunkban is. Az eredmények pedig azt sugallják, hogy bár sok mikroba él a környezetünkben, nem minden vírus veszélyes ránk, sőt, a jövőben akár orvosi célokra is felhasználhatjuk őket.
Legyőzhetők a szuperbaktériumok? Magyar kutatók új felfedezése!
Kövesse az Egészségkalauz cikkeit a Google Hírek-ben, a Facebook-on, az Instagramon vagy a X-en,Tiktok-on is!









